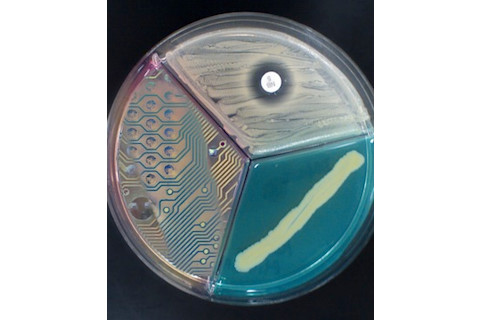

当我想到超人类主义时,我会想到基因工程、认知增强药物和神经骨骼整合假肢。当《连线》杂志的采访对象 Lepht Anonym 思考超人类主义时,她想到的是厨房水槽手术,用热熔胶作为生物防护剂,用伏特加作为消毒剂。Anonym 是一个生物黑客,或者说一个“改造者”,这取决于你喜欢的称谓。改造是一种反主流文化的思维方式,其根源在于赛博朋克和后现代主义对进步的幻灭。生物黑客们进行身体改造,在家进行手术,并加入了电磁频谱的元素。Anonym 似乎介于两者之间。
一位具有相似思维的美国身体改造艺术家[与 Anonym 相似] 创造了由钕金属制成的小型圆盘,这些圆盘涂有金和硅,在电磁场中会发出微弱的电流。当植入指尖下时,这种电流会刺激手指的神经末梢,使佩戴者能够真实地感受到电源线或电子设备周围电磁场的形状和强度。Anonym 曾让几个人专业地植入了这些装置,但觉得价格太贵,后来发现自己可以大量购买这些金属,价格便宜得多。于是她开始尝试自制传感器。金属本身有剧毒,所以她需要一种涂层来对其进行生物防护,最终找到了一种名为 Sugru 的硅胶腻子状物质。但她也表示,热熔胶效果也很好。(“我体内有很多东西是用热熔胶包裹的,”她说。)
Anonym 认为学术上的超人类主义者(也就是我)“很没劲”。我最初的想法是“这不是超人类主义者,这是个疯子!”每当我被某人的行为吓到时,我都会觉得自己老了,思想保守了。为了摆脱这种感觉,我去找那些老派、保守的人的想法。Charles T. Rubin 在《新亚特兰蒂斯》杂志的 Futurisms 博客上乐于满足了我的愿望。Rubin 担心像 Anonym 这样的生物黑客代表了一种对“自残”的颂扬,以及我们的社会无法将她的行为视为她真正需要的求助信号。Rubin 关于 Anonym “自残”的担忧帖子让我意识到,困扰我的不是她的态度或审美。除了不明智的技术(伏特加消毒?酒精更便宜,而且,呃,实际上是无菌的!),我倒是很认同生物黑客和改造的总体精神。但相反,我意识到我根本不知道 Anonym 为什么要进行这些改造。RFID 芯片有点用,但钕磁片的麻烦似乎只换来了微小的回报。所以你能感受到电流。很酷,我猜?既然这些都不是非法的,那么自残手术就显得像是一种“看看我有多硬核”的态度,而不是一种真正的反抗行为。除非这些改造能赋予一个人超越普通人的*有用*能力,否则像 Anonym 这样的人,只是找到了新方式来取乐的身体改造者。很酷,是的,但并不比穿孔或纹身更超人类。原始图片来自anicole
和quapan 在 Flickr Creative Commons













